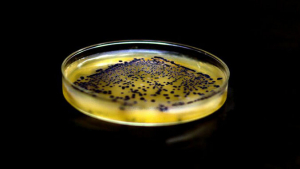

UH Hilo Biochemists Seek To Control Cancer Through Cell Division Research
Associate Professor of Biology Li Tao at the University of Hawaiʻi at Hilo is doing research into the mechanisms of cell division to find clues for cancer treatment, and has published his most recent findings in Science Signaling.
 Li Tao, right, and Brandt Warecki The study was conducted primarily by Tao and Brandt Warecki, who holds a joint postdoctoral position between UH Hilo and University of California, Santa Cruz. Warecki is lead author of the study; Tao serves as corresponding author.
Li Tao, right, and Brandt Warecki The study was conducted primarily by Tao and Brandt Warecki, who holds a joint postdoctoral position between UH Hilo and University of California, Santa Cruz. Warecki is lead author of the study; Tao serves as corresponding author.
Tao is a biochemist and cell biologist with expertise in using a combination of in vitro biochemistry and in vivo cell biology to understand the regulation of cell division, providing insights into the fundamental mechanism to control the growth of cancer cells.
The recently published findings from Tao’s lab highlight that centralspindlin, a motor complex implicated in cell division, plays a pivotal role in dictating cytokinesis (cell division) by transporting essential components required to initiate this process.
Finding clues for cancer treatment
In a 2016 study, Li Tao’s research team used molecular cloning to engineer new kinesin constructs. (Photo credit: Claudia Hagan, UH Hilo Stories)
In a 2016 study, Li Tao’s research team used molecular cloning to engineer new kinesin constructs. (Photo credit: Claudia Hagan, UH Hilo Stories)
Tao says his research into the mechanisms of cell division will provide clues for cancer treatment.
“Abnormal cell division causes cancer,” he explained. “Understanding the mechanism of cell division and its control has thus become a key to find cures for cancer.”
Tao’s ultimate goal is to have a greater understanding of how mitotic motors regulate cell division, which will help find an effective way to cure cancer.
Tao believes the success of this mission depends on collaboration among peers.
“In my opinion, solving problems on cell division should be teamwork with experts from various fields,” he said.
For the full story visit UH Hilo Stories.
—By Susan Enright
Publication: Brandt Warecki, et al. Centralspindlin-mediated transport of RhoGEF positions the cleavage plane for cytokinesis. Science, (2023). DOI: 10.1126/scisignal.adh0601
Original Story Source: University of Hawaii at Manoa

 Alerts Sign-up
Alerts Sign-up